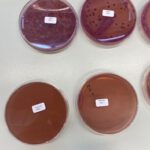
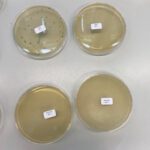

von Rinesa Ismaili
Ich habe in den Herbstferien im Rahmen der Auricher Wissenschaftstage ein Praktikum am Bundesinstitut für Risikobewertung in Berlin absolviert. Dort war ich in der Fachgruppe für Lebensmittelhygiene und -technologie, Warenketten, Produktschutz der Abteilung Biologische Sicherheit am Standort in Marienfelde und wurde von Felix Reich betreut. Diese Fachgruppe ist für die Bewertung mikrobieller Risiken von Lebensmitteln unter spezieller Berücksichtigung der Lebensmittelhygiene zuständig. Die Aufgabe besteht darin zu kontrollieren, inwiefern Mikroorganismen in Lebensmitteln die Verbraucher gefährden.
Mein erster Tag begann gegen 10 Uhr am BfR in Marienfelde. Generell habe ich die folgenden Tage um neun Uhr begonnen und arbeitete täglich ungefähr bis 16 Uhr. Ich durfte schon am Montagmorgen ein Kolloquium online miterleben. Dort wurde ein wissenschaftlicher Vortrag zur Identifikation von Brucellose, mit Hinblick auf Risikobewertung in Deutschland, gehalten. Man fokussierte sich auf jährliche Fälle und die Infektion mit dem Erreger Brucella-canis, welcher vom Hund als Haustier auf den Menschen übertragbar ist.
Nach diesem wissenschaftlichen Start in die Woche, lernte ich die Mitarbeiter/innen kennen und erhielt schon Einblicke in laufende Projekte. Außerdem verschaffte ich mir einen Überblick über die Räumlichkeiten und die Labore am Institut. Darüber hinaus erklärte mir Herr Reich, wie wir in den nächsten zwei Wochen vorgehen werden.
Am nächsten Tag wurde mir das Labor gezeigt. Dort waren viele Regeln und Prinzipien zu beachten, wie z.B. die strenge Hygiene, um Infektion mit Erregern zu vermeiden. Anschließend durfte ich meinen eigenen Laborkittel auswählen, den ich in den nächsten zwei Wochen am Institut getragen habe.
Meinen ersten Tag im Labor verbrachte ich damit, die verschiedenen Pipetten zu benutzen und neue Geräte kennenzulernen. Am Nachmittag besuchten wir die Technologie, wo z.B. die Schlachtung von Tieren, die untersucht werden sollen, stattfindet. Kurz vor Schichtende sollte ich noch meinen Versuch vorbereiten. Dazu stellte ich 18 Reagenzgläser mit jeweils 9 ml MRD (Natriumchloridlösung als Verdünnungsmittel) zum Kühlen ab und beschriftete die Petrischalen für die anstehende mikrobiologische Untersuchung.
Am Mittwoch durfte ich an einer wissenschaftlichen Veranstaltung von 9 bis 16 Uhr teilnehmen. Die Veranstaltung handelte von einem Projekt namens „Alma“. Vor kurzem wurden fünf Kühe am Institut zu wissenschaftlichen Zwecken getötet und die Organe gingen an viele verschiedene Forscher, die nicht nur am BfR tätig waren. Dabei lag der Fokus auf dem „3R“-Prinzip, welches für den Tierschutz erzielen möchte, Tierversuche zu vermeiden (Replace) und die Zahl an Tötungen von Tieren zu reduzieren (Reduce), sowie das Tierleid (Refine) auf das Nötigste zu beschränken. Dabei wurden hier „Almas“ Organe für wissenschaftliche Zwecke vollständig genutzt, wodurch man die Zahl an Tötungen minimieren konnte. Der Vortrag bezog sich auf den verschiedenen Organen. Die Wissenschaftler stellten ihre erworbenen Erkenntnisse an Almas Organen vor. So erfuhr ich Wissenswertes über die Untersuchungen des Gehirns, der Leber und Milz und weitere Organe. So stellt das Gehirn der Kuh eine Brücke zum Menschen dar, da vorher viel an Mäusen erforscht wurde. Die Veranstaltung endete mit einer Diskussionsrunde und einer Reflexion des Projektes. Man wolle in der Zukunft häufiger Organsharing betreiben, um so die Anzahl an Tötungen zu vermindern und so möglichst viele Erkenntnisse an einem einzigen Tier zu gewinnen. Dabei schlug man u.a. vor, ein Portal zu erstellen, bei dem sich interessierte Forscher für ähnliche Aktionen anmelden können, um online an solchen Untersuchungen teilnehmen zu können.
Am vierten Tag begann mein Projekt „Fermentation von Milch – Käseherstellung“. In der Technologie durfte ich Käse herstellen und am späteren Nachmittag den Käsebruch sowie die dafür verwendete Milch mikrobiologisch untersuchen.
Zu Beginn musste die Rohmilch in einem Wasserbad auf 35°C erwärmt werden. Wir hatten Milchsäurebakterien in einer Mischkultur zur erwärmten Milch hinzugegeben. Dabei handelte es sich um eine Weichkäsekultur und eine Weißschimmelkäsekultur. Davon wog ich jeweils 1,2 g ab.
Nach dem 60-minütigen Reifen der Milch fügte ich 2 ml Lab hinzu. Lab ist ein Gemisch aus den Enzymen Chymosin und Pepsin, welches die Gerinnung der Milch fördert. Es folgten erneut 40 Minuten Wartezeit, bevor wir mit dem Schneiden beginnen konnten. Hierbei achtet man auf die Art und Weise des Schneidens, um möglichst den gewünschten Käse zu erhalten. Wir entschieden uns für 2,5 cm breite Stücke, die nach 10 Minuten noch zu Würfeln geschnitten wurden. Anschließend konnten wir mit der Käseharfe die Stücke zu Käsebruch zerkleinert werden. Mit dem Schneiden begann nämlich auch die Synärese, welche den Austritt der Molke beschreibt. Dabei ist es wichtig den Käsebruch im späteren Verlauf von der Molke zu trennen. Der Käsebruch wurde in mehreren Abständen von jeweils 15 Minuten immer wieder kontrolliert. Nach 45 Minuten haben wir die Molke vom Käsebruch getrennt. Dabei verwendeten wir Käseformen mit Löchern. Beim Auffüllen der Formen trat die Molke aus und der Käsebruch verblieb in der Form. Dadurch verwandelte sich der Käsebruch jeweils zu einem Käsestück. Nach 5 Minuten musste der Käse in der Form gewendet werden – daraufhin jeweils drei weitere Male im 30 Minuten Abstand. Zwischendurch musste das weitere Abtropfen gewährleistet sein. Daher legten wir die Formen auf eine für Molke durchlässige Platte. Wir ließen den Käse 12 Stunden abtropfen, bevor er in ein Salzbad gelegt wurde. Das Salzbad bestand aus 250 ml Kochsalz und 750 ml Wasser. 100 g Käse werden 50 Minuten ins Salzbad gelegt, 200 g für 90 Minuten. Das Salzen ist sehr wichtig, um dem Käse den beabsichtigten Geschmack zu geben. Dieser Schritt ist entscheidend für die Qualität des Käses. Abschließend reift der Käse 12 Tage lang bei einer Luftfeuchtigkeit von 95%.
Der Käseherstellung folgten dann am selben Tag noch die Käsebruch- und die Rohmilchuntersuchungen. Beide Produkte werden auf verschiedene Keime untersucht. Die Petrischalen werden mit den Fachausdrücken TBX, MRS, PC und VRBD beschriftet. TBX ist ein Nährboden, auf welchem man E. coli nachweisen kann. Mit MRS weist man Milchsäurebakterien nach. PC steht für die Gesamtkeimzahl und VRBD für die Enterobacteriaceae. Der Nährboden dient dazu, Bakterien bzw. deren Kolonien nachzuweisen.
Die Rohmilchuntersuchung beginnt damit, dass man eine Verdünnungsreihe startet. Die Verdünnung muss in einem Verhältnis von 1:10 sein. So nahmen wir 1 ml Rohmilch und fügten sie zu 10 ml MRD hinzu. MRD ist ein Verdünnungsmittel, welches aus Pepton und einer Kochsalzlösung besteht. Die Verdünnungsreihe endet mit der achten Verdünnungsstufe, in der man 1 ml Flüssigkeit der vorherigen siebten Stufe mit 10 ml MRD mischt. Für die folgenden Untersuchungen entnahm ich für die beschrifteten Petrischalen 1 ml jeder der acht Verdünnungsstufen. Wenn auf die Petrischalen für TBX/PC/VRBD die 1 ml pipettiert worden sind, nutzte ich das Gussverfahren und füllte 20 ml des benötigten Agars hinzu (für E. coli z.B. TBX-Agar). Nachdem der Agar fest geworden war, mussten die Ansätze in den Brutschrank gebracht werden. Je nachdem welche Bakterien man nachweisen wollte, mussten die Ansätze unterschiedlich lange im Brutschrank bleiben. Die Aufbewahrungszeiten variierten zwischen 24 und 72 Stunden, die Temperaturen reichten von 25°C bis zu 44°C.
Für die Milchsäurebakterien wurden nur 0,1 ml pipettiert, da man dafür das Oberflächenverfahren nutzte. Der Nährboden war nämlich bereits in der Petrischale und ich musste die 0,1 ml mit einem Spatel verteilen. Die MRS-Platten kamen beispielsweise für 72 Stunden bei 25°C in den Brutschrank.
Die Käseuntersuchung verlief generell nach dem gleichen Prinzip wie die Rohmilchuntersuchung. Das Problem war jedoch, dass die Konsistenz des Käsebruchs es nicht ermöglichte, die Verdünnungsreihe manuell zu starten. Bei der Untersuchung des Käses füllten wir einen Beutel mit semipermeabler Membran mit 90 ml MRD auf und gaben 10g des Käsebruchs hinzu. Dann legten wir diesen Beutel in einen BagMixer, der mit Paddeln den Inhalt des Beutels durchmischte. Dadurch So wurde aus dem 10g Käsebruch eine Mischung aus Käsebruch und MRD, die wir nun pipettieren konnten. Daran schloss sich die Erstellung einer Verdünnungsreihe und derselbe Ablauf wie bei der Rohmilchuntersuchung an.
Am Montag der zweiten Woche beschäftigte ich mich mit meinem anstehenden Referat zur Fermentation von Milch und der mikrobiologischen Untersuchung der Rohmilch und des Käsebruchs. Außerdem konnte ich nun auch die Platten für PC und MRS auszählen, um im Anschluss die Zahl der Kolonien interpretieren zu können. Außerdem wurde mir die Formel für die Berechnung der Keimzahl gegeben, die ich nun auf meine Ergebnisse anwenden konnte.
Für die Anzahl N der Keime gilt: N=
Die Berechnung ergab für den Käsebruch 3*102KbE/g E.coli und 3,8*108 KbE/g Gesamtkeime. Außerdem fanden wir 5,4*106KbE/g Milchsäurebakterien und 7,7*103 KbE/g Enterobakterien.
Die Rohmilchuntersuchung ergab weniger als 101KbE/ml E. coli und 5,5*108 KbE/ml Gesamtkeime. Darüber hinaus enthielt die Rohmilch weniger als 105KbE/ml Milchsäurebakterien. Auf der Petrischale der Enterobakterien in der Rohmilch war nur eine Laufkolonien der zweiten Verdünnungsstufe sichtbar.
An dieser Stelle fragten wir uns, wie diese zustande kommen konnte, wenn auf der ersten Verdünnungsstufe nichts zu sehen war. Bestünde die sichtbare Kolonie auf der zweiten Verdünnungsstufe wirklich aus Enterobakterien, so müsste man unter Berücksichtigung der Verdünnung das 10-fache an Kolonien auf der ersten Stufe sehen können. Durch das MALDI-Verfahren am Dienstag stellte sich heraus, dass es keine Enterobakterien waren. Der MALDI-TOF ist ein Gerät, welches bei der Identifikation von Bakterien hilft. Man setzt dafür die zu untersuchende Kolonie auf einen Träger, nachdem man die Kolonie in einer bestimmten Matrix gelöst hat. Der Träger wird in das Gerät eingesetzt und durch einen Laser ionisiert. Die in den Bakterien enthaltenen Proteine werden durch eine time-of-flight-Analyse abgetrennt, wodurch ein Massenspektrometer entworfen wird. Dadurch konnte der MALDI die Laufkolonie identifizieren. Die Bakterien wurden als Acinetobacerpittii identifiziert, welches nicht zu den Enterobakterien gehören und somit auch nicht auf die VRBD-Platte.
Abschließend werteten wir noch die Proben aus, die eine Mitarbeiterin für die Salmonellen und Listerien in der Rohmilch und im Käse angesetzt hatte. Dort war jedoch nichts zu sehen und somit waren auch keine Listerien oder Salmonellen im Käse oder in der Rohmilch enthalten.
Verglichen mit den Grenz- und Richtwerten der Ladr-Labors in Hannover ist die E. coli-Anzahl im Käse im zulässigen Bereich und somit als ungefährlich zu bewerten.
Die Gesamtkeimzahl in der Rohmilch ist deutlich über dem Grenzwert von 105 KbE/ml. Daher sollte auf den Verzehr von Rohmilch verzichtet werden. Dieses bestätigte das BfR bereits im Jahr 2016, nachdem die Rohmilch auf Campylobacter untersucht wurde und festgestellt wurde, dass das Risiko einer Infektion sinkt, wenn die Rohmilch abgekocht wird. Diese Risikobewertung aus dem Jahr 2016, enthielt den Vorschlag, die Verpackung der Rohmilch mit dem Hinweis zu kennzeichnen, dass das Produkt vor Verzehr abgekocht werden sollte. Dadurch würde das Risiko auf eine Infektion mit Campylobacter verringert werden.
Am Mittwoch durfte ich an den Vorversuchen einer Doktorandin teilnehmen. Außerdem stand für den Tag die Präsentation meines Projektes an, welche erfreulicherweise sehr gut verlief. Darin stellte ich meine Erkenntnisse der letzten Woche dar und berichtete über die Käseherstellung und meine mikrobiologischen Untersuchungen.
Außerdem war ich in der ZNB (Zentraler Nährmedienbereich), wo ich auch die Arbeit hinter den Kulissen miterleben konnte. In diesem Bereich wird bspw. Agar hergestellt oder MRD für die Fachgruppen angesetzt. Alle Bestellung für verschiedenste Medien werden über die ZNB abgewickelt. Ich durfte auch MRD ansetzen und acht Gefäße mit MRD befüllen, welche direkt an unsere Abteilung ging. Diese Arbeit ist mit sehr viel Aufwand verbunden und sollte nicht unterschätzt werden, denn die verschiedenen Abteilungen sind abhängig von den Vorbereitungen in der ZNB. Die zahlreichen Bestellungen und Vorarbeiten müssen in kürzester Zeit bearbeitet werden, um den Forschern am BfR die Arbeit zu ermöglichen.
Auch bei Routineaufgaben, wie dem Sortieren von Pipettenansätzen, durfte ich mitwirken und so mein Erfahrungsspektrum am Institut erweitern.
Zusammenfassend kann ich sagen, dass mir das Praktikum sehr gut gefallen hat. Die Möglichkeit Wissenschaftler begleiten zu dürfen und auf diese Weise mein Wissensspektrum so zu erweitern, weiß ich sehr zu schätzen. Abgesehen davon, habe ich durch das Praktikum gelernt, dass man sich in Deutschland mit einem Medizinstudium in sehr viele verschiedene Fachrichtungen spezialisieren kann und somit die möglichen Berufe schon im selben Studiengang sehr variieren können.
Letztendlich möchte ich mich sowohl beim BfR, Felix Reich sowie als auch bei den Auricher Wissenschaftstagen bedanken, dass ich diese Chance eines Stipendiums erhielt und somit in den Herbstferien als Schülerin lehrreiche Einblicke in die Welt der Wissenschaft erhalten habe.